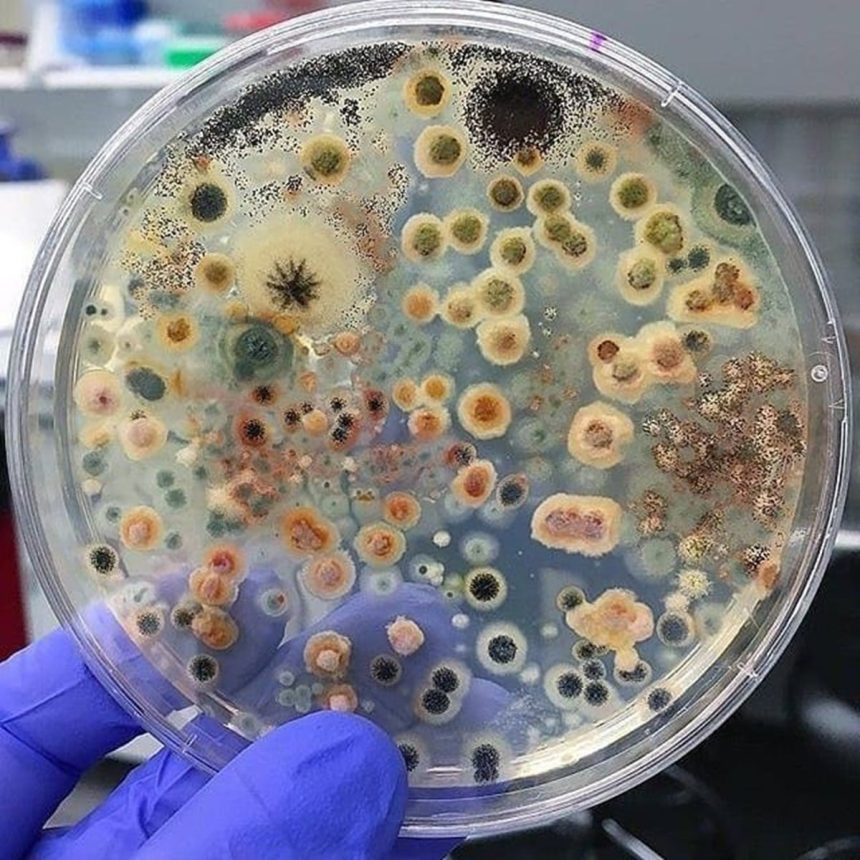
Beyaz gürültü dinletilen petri kapları sessizce saklanan petri kaplarıyla karşılaştırıldığında, beyaz gürültüye maruz bırakılanlar en büyük büyümeyi gösterdi. (Görsel: Pinterest)

Beyaz gürültü bazı mikroorganizmaların gelişmesine yardımcı olur.
Carly Cassella
Çeviri: Emine Öykü Güner
Mantarların kulakları olmayabilir. Ancak mantarlar çevrelerindeki seslere göre büyümelerini ayarlayabilir. Araştırmacılar Trichoderma harzianum adlı mantar türüne radyo paraziti gibi yüksek frekanslı, tekdüze bir çıtırtı verildiğinde organizmanın normalden çok daha hızlı büyüdüğünü ve spor ürettiğini keşfetti. Bu durum mantarlar da beyaz gürültüyle besleniyormuş gibi bir etki yarattı.
Bu önemli bir bulgudur. Çünkü T. harzianum neredeyse toprakların tümünde bulunur. Bu mantar ( T. harzianum ) bitki köklerini kolonize edip büyümeleünerini artırdığı bilinmektedir. Çiftliklerde, bu tür bitkilere zarar verebilen patojenik mantarları parazitleyebilir. Dolayısıyla, çevreciler belirli sesleri çalarak dünyanın dört bir yanındaki çok sayıda yaşam alanında ve tarım alanında daha sağlıklı topraklar oluşturabilirler.
Avustralya’daki Flinders Üniversitesi’nde araştırmayı yöneten mikrobiyal ekolojist Jake Robinson, “Bozulmuş topraktaki faydalı mantarların ve diğer mikropların seviyelerini hızlandırıp onları iyileştirmek için yeni yollar bulmaya çalışıyoruz” diyor. O ve ekibi, araştırmalarının (bozulmuş yaşam alanları ve tarım arazilerini restore edip dünyayı besleyerek) geniş faydalar sağlayacağını umuyor.
Deneylerde araştırmacılar, beş gün boyunca ses geçirmez odalarda tutulan T. harzianum’un petri kaplarına 30 dakika boyunca beyaz gürültü dinlettiler. Beyaz gürültü dinletilen petri kapları sessizce saklanan petri kaplarıyla karşılaştırıldığında, beyaz gürültüye maruz bırakılanlar en büyük büyümeyi gösterdi.
Bu özel toprak mantarının (T. harzianum ) beyaz gürültü varlığında nasıl daha hızlı büyüdüğünü ve aynı etkinin laboratuvar dışında da meydana gelip gelmediğini anlamak için daha fazla araştırmaya ihtiyaç vardır. Ayrıca mantarların artan büyümesinin bitki veya bakteri büyümesini artırıp artırmadığı da belirsizliğini korumaktadır.
Flinders Üniversitesi’ndeki ekip, “Çalışmamız ekosistem restorasyonunu teşvik etmek için sesin yenilikçi bir araç olarak kullanılması noktasında önemli bir adım teşkil ediyor” diye yazıyor.
Bilim insanlarının mantarları sesle tedavi etmeye çalışması ilk değil. Örneğin istiridye mantarı çiftçilerinin miselyumlarının** her beş günde bir belirli seslerle tedavi etmesi sonucunda meyve veren gövdelerin büyüdüğü kaydedilmiştir.
Ancak seslerin kullanımı her zaman yararlı değildir. Aynı zamanda zararlı da olabilir. 2020 yılında araştırmacılar, buzdolaplarının uğultusunun dünya çapında meyve ve sebzeleri çürüten patojenik bir mantarın büyümesini artırdığını keşfetti. Laboratuvarda bu yüksek frekanslı buzdolabı seslerinin çalınması çürümeyi yüzde 18’e kadar artırdı.
T. harzianum örneğinde, beyaz gürültü varlığında mantarın neden daha hızlı büyüdüğü ve daha fazla spor ürettiği belirsizdir. Robinson ve ekibi, ses dalgalarının organizmanın reseptörlerini mekanik olarak aktive ettiğinden şüpheleniyor. Bu mekanik sinyal daha sonra ya elektriksel bir voltaja ya da biyokimyasal bir sinyale dönüştürülüyor. Eğer bu bir biyokimyasal sinyal ise, bu mantarın gen ifadesini veya hücre üretimini değiştirebilir.
Robinson ve meslektaşlarının daha az olası olduğunu söylediği bir elektrik sinyaline dönüştürülürse, bu durum mantarların daha iyi iletişim kurmasını sağlayabilir. Mantarların sinir benzeri elektriksel aktivitesi yakın zamanda insan konuşmasıyla karşılaştırıldı. Sonuç gösteriyor ki elektrik sinyali mantarların organizmasının bütünlüğünü korumaya yardımcı olabilir.
Bu konu henüz erken aşamalarında olan bir araştırma alanıdır. Ancak kanıtlar, mantarların, bakterilerin ve bitkilerin sese ilgi çekici ve muhtemelen yararlı şekillerde yanıt verebildiğini giderek daha fazla öne sürüyor.
*Beyaz gürültü, farklı frekanstaki seslerin birleşmesi ile oluşan ve sürekli devam eden sesler bütünüdür.
** Miselyum, genellikle yeraltında bulunan (ya da birtakım başka maddelerin içinde olan) mantarın bölümüdür. Miselyum yer altının nöral ağı gibidir. Trilyonlarca uzantıları vardır. Bitkilerin birbirleriyle besin paylaşmasına olanak sağlarlar.
Kaynak:
https://www.sciencealert.com/white-noise-is-like-music-to-these-microbes-and-it-helps-them-thrive (son erişim tarihi: 3.10.2024)